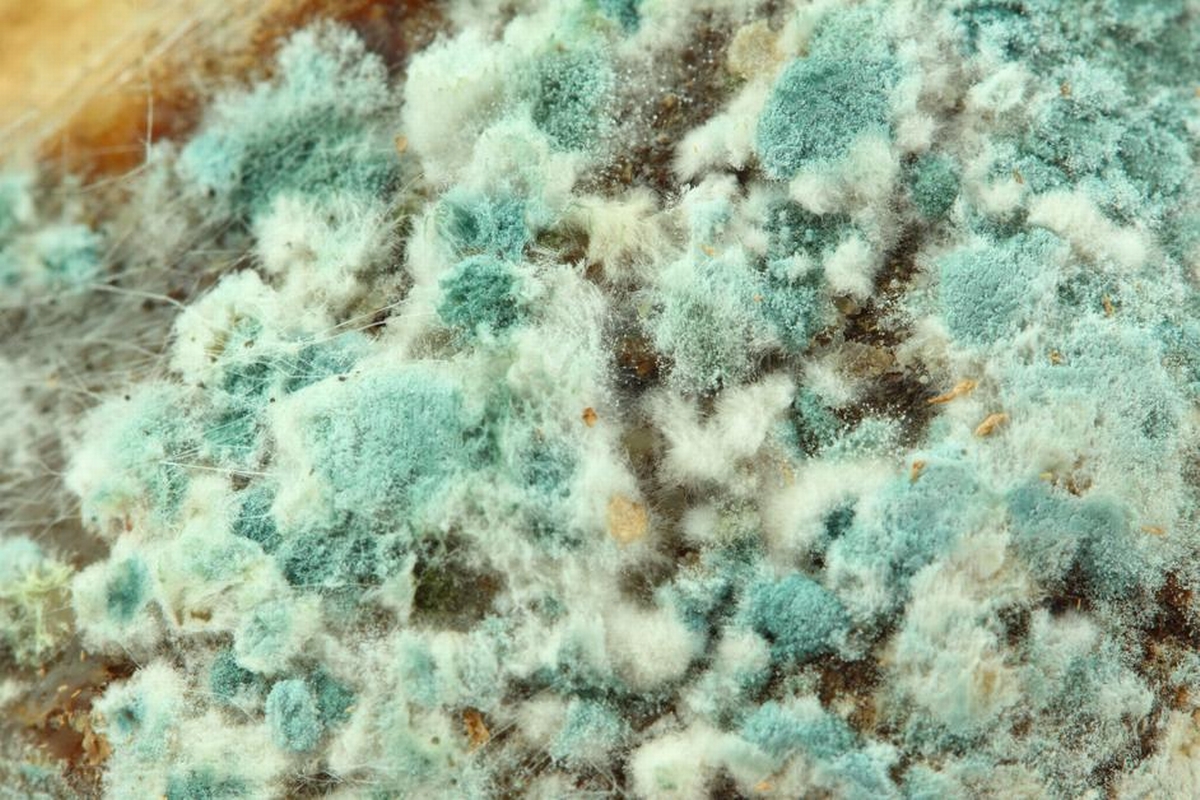
What Is Mold Mitigation and Why It Matters

Getting Mold? How Long Does It Take Black Mold to Grow
June 17, 2026
When it comes to environmental hazards within the home, few issues can be as insidious and pervasive as mold. Mold doesn't merely damage buildings; it poses significant health risks as well. Understanding what mold mitigation is is crucial, especially when considering a reputable damage restoration company in Madison and its nearby regions, like Dry Source Property Restoration, which specializes in a range of restoration and remediation services. Mold mitigation is a process that stops current mold growth and prevents future reoccurrence, protecting both homes and the people who inhabit them.
Mold thrives in areas with excessive moisture, often emerging after water damage incidents or in naturally damp areas of the house. Left unchecked, it can impact air quality and significantly harm the structural integrity of a property. This article will explore what mold mitigation is, why it matters, and how engaging with a professional service can safeguard your home and health. We will provide insights into how mold occurs, steps involved in mold mitigation, and highlight the importance of professional remediation efforts.
Before diving into the intricacies of mold mitigation, it's vital to understand what mold is and how it impacts environments. Mold is a type of fungus that grows from tiny spores in the air. When these spores land on a moist surface, they begin to grow, and eventually, colonies can form.
The presence of mold is more than an aesthetic issue. Mold releases spores that can become airborne and inhaled. This poses significant health risks, ranging from minor allergic reactions to severe respiratory issues. Those with pre-existing respiratory conditions, allergies, or weakened immune systems are particularly vulnerable.
Furthermore, mold exposure can trigger asthma attacks, skin irritation, and even more severe conditions, such as chronic fatigue or pulmonary disorders, over prolonged exposure. Mold mitigation becomes crucial to eliminate these health hazards and ensure a safe living environment.
From a structural standpoint, mold can weaken and destroy building materials. Wooden structures, drywall, and even concrete can become compromised if mold growth is left unmanaged. This degradation not only affects the durability of the home but can also lead to high repair costs if critical structures are damaged. Therefore, understanding what is mold mitigation and implementing effective strategies to prevent mold from proliferating is essential for preserving property value.
Mold mitigation involves a comprehensive approach to addressing mold growth in a property. The process typically includes the following steps:
Engaging a professional damage restoration company in Madison, WI for mold mitigation presents numerous advantages. Experts like those at Dry Source Property Restoration have the experience and equipment necessary to efficiently and safely carry out the mold mitigation process. If you're considering services like mold removal and remediation in Madison and its neighboring communities, professionals should be your first call for ensuring comprehensive and effective results.
Professionals bring a wealth of experience and expertise to the table. They are trained to deal with all types of mold and understand the different methodologies required for effective removal and prevention. By hiring experts, homeowners can rest assured that the job will be handled with precision and care.
One of the primary goals of mold mitigation is to not only address the current infestation but also prevent future occurrences. Professionals use industry-standard tools and techniques to identify moisture sources and rectify them, ensuring that mold doesn’t return.
Beyond technical expertise, professional services offer peace of mind. Knowing that your environment is safe and that the risk of mold-related health issues is minimized allows homeowners to focus on living comfortably and healthily.
In Madison, the climate can contribute to mold challenges, making local specialists like Dry Source Property Restoration even more invaluable. They understand the regional issues that lead to mold and employ customized solutions to address these effectively. Additionally, seeking out services such as residential and commercial reconstruction in Madison after significant mold damage ensures properties are restored thoroughly and safely.
Mold is more than just an inconvenience—it's a serious threat to health and property. By understanding what is mold mitigation and the steps involved, homeowners can make informed decisions about managing mold issues effectively. Prioritizing mold mitigation protects the health of the people in your home and maintains or increases the value of the property.
The financial implications of ignoring mold issues can be steep. Damage repairs can be costlier than preventative actions, not to mention the potential medical costs due to health complications from living in mold-infested spaces.
Choosing the right partner in mold mitigation is key. Beyond the Madison area, services like sewage cleanup and removal in Monona can be critical adjuncts to mold mitigation, especially after flooding incidents. Connecting with experts who understand these concerns and provide tailored remediation services is vital.
If you're a homeowner grappling with mold issues, engaging with a professional restoration company is a proactive step towards safeguarding your investment and health. Dry Source Property Restoration, servicing Madison and beyond, offers expertise in mold removal and remediation, fire damage, and water damage restoration, ensuring your home remains safe and comfortable.
Engaging with Dry Source Property Restoration can provide significant peace of mind. Secure your home environment today by taking advantage of their professional services—a safe, mold-free home begins with a simple call to action.
Explore the expertise of Dry Source Property Restoration for comprehensive protection against mold and other property restoration needs. Contact Dry Source Property Restoration today. Their teams are ready to assist you in creating a healthier, safer living space.
June 17, 2026
June 15, 2026
June 1, 2026